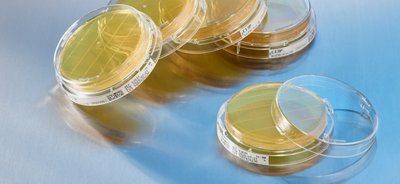
3P SMART PLATES

Environmental Monitoring for Pharmaceuticals
ENVIRONMENTAL MONITORING
In microbiology and pharmaceutical development, environmental monitoring (EM) is a process that determines the quality of a controlled environment via microbial data collection. Data comes from samples of air, surfaces, and personnel in a clean space. Environmental monitoring plays a critical role in developing sterile (ie: injection, infusions, ophthalmic solution) and non-sterile (ie: solutions, capsules, tablets, ointments) drug products.
WHY IS IT IMPORTANT?
Drugs contaminated by microbes can cause immediate and long-term harm to patients treated with these products.. Microbes also alter the chemistry and pharmacology of drugs, which breaks down the active ingredients and impacts the product's efficacy. When combined with robust environmental monitoring, microbiological testing ensures that a drug is safe and effective. Environmental monitoring is part of the regulatory compliance are part and mandatory of the GMP process and must be provided in order to allows the release of the final product.
APPLICATIONS OF ENVIRONMENTAL MONITORING
Environmental monitoring evaluates the quality of air, surfaces, and personnel through testing and sample analysis. Meeting appropriate hygiene standards is essential to the safety and efficacy of a finished product.
Air Monitoring
The air quality of any lab or production area is critical, as microorganisms in the air increase the risk of ingredients and products becoming cross-contaminated. According to the CDC, biological contaminants in the air may include bacteria, fungi, viruses, and pollens.
Laser particle counters or active air samplers are used to retrieve air samples. These samples are incubated and analyzed for the presence of microorganisms. If there is microbial contamination in the air, an identification test determines the origin of the microorganism. This step of environmental monitoring is vital for manufacturers of pharmaceuticals, cosmetics, food, and beverages.
Personnel Monitoring
Even with hygiene practices and proper PPE (gowns, gloves, goggles, face shields, and N95 masks), humans are the most significant risk of source of contaminants to an aseptic environment.
Individuals can easily perform personnel testing on themselves in one of two ways: swabbing the forehead or elbows with a cotton swab dipped in tryptic soy broth (TSB) or direct contact with a tryptic soy agar (TSA) plate and the fingertips. Plates will then be covered and incubated for about 18 hours before checking if microbes are present.
Surface Monitoring
No matter how thoroughly a lab or cleanroom has been sanitized, microorganisms can quickly transfer from one surface to another by touching the surface with something that is contaminated.
When testing a surface for microbes, an agar plate is directly placed on a surface and then covered and incubated. Personnel should then spray down the surface with isopropyl alcohol for further disinfection.
REGULATIONS AND RULES
Aseptic processing is a manufacturing method that produces pharmaceutical products that are free from bacteria. Regulatory agencies like the FDA and the European Medicines Agency (EMA) require pharmaceutical manufacturers to have an environmental monitoring program in place to ensure that aseptic processing is possible. New Annex 1 emphasizes the need for a strong and robust environmental monitoring.
Requirements For Environmental Monitoring
According to American Pharmaceutical Review, all EM programs should use a combination of the following methods:
- Settle plates (air testing)
- Contact plates (surface and personal testing)
- Surface/personnel swabs
- Active air samples
- Rinse samples
BIOMÉRIEUX ENVIRONMENTAL MONITORING SOLUTIONS
bioMérieux offers customized EM solutions to ensure that your work meets compliance and regulatory standards. Feel confident about the products you’re releasing with our active air sampler and environmental monitoring culture media.
Quality Control monitoring in microbiology is critical and challenging for pharmaceutical companies. While hand transcription remains the standard procedure in use, these daily processes often result in errors leading to time-consuming investigations, and data that isn’t fully compliant.
At bioMérieux, we are strongly committed to empowering our customers in keeping control of their production environment. We believe that digitalizing and automating your entire Environmental Monitoring process, from sampling to analysis, will support your desire to limit uncertainty while enhancing productivity. These changes are by no means an easy task, but by engaging with bioMérieux experts, end-to-end Environmental Monitoring can become not too far a future!



